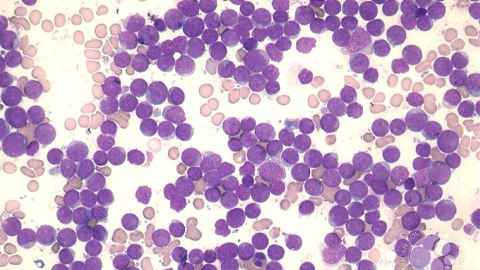
Rates of some blood cancers were 20 percent higher in patients from areas of high deprivation.   Image: ASH Collection.

Poverty drives up blood-cancer deaths
17 December 2025
Socioeconomic deprivation is linked to lower survival times and higher rates of some blood cancers, new research from the University of Auckland shows.

New research from the University of Auckland has found socioeconomic deprivation is linked to lower survival times and higher rates of some blood cancers.
The study of 3500 adults with acute myeloid leukaemia (AML) found strong links between poverty and poorer survival times in New Zealand, says Dr Maggie Kalev, a senior lecturer in cancer biology, who works part-time at Auckland Hospital as a laboratory haematologist.
Overall, the study found a 15 percent higher risk of death in adults with the blood cancer who lived in areas of socioeconomic deprivation, compared with those from wealthier suburbs, says Kalev.
Rates of AML were 20 percent higher in poorer areas, suggesting deprivation plays a role in developing the disease.
“New Zealand has a universal public healthcare system, so we didn’t expect deprivation to have a significant impact on survival.
“This highlights the need to address deprivation, because that has the potential to improve people’s health on multiple levels, including cancer,” says Kalev, from the University’s Centre for Cancer Research.
Deprivation was linked with poorer survival, regardless of the patient’s ethnicity. However, Māori and Pacific patients were more than twice as likely to come from areas of high deprivation (61.9 percent), compared with European patients (27 percent), says Kalev.
Her team at the Blood and Cancer Biology Lab used data from the New Zealand Cancer Registry on patients diagnosed with AML between 2000 and 2019 for the study.
It found an overall rate of AML of 2.59 per 100,000 adults, but the rate for Māori was 3.13 per 100,00.
Māori were significantly younger when diagnosed, with a median age of 57, compared with 71 for Europeans.
Kalev led another new study, which found that children with acute leukaemia who come from areas of high deprivation do not suffer the same reduced survival times as adults.
“This suggests the effects of deprivation are better addressed when children are treated for blood cancer, or that deprivation worsens people’s overall health as they age,” says Kalev.
The social and economic needs of families of children with blood cancer are comprehensively assessed, and more wrap-around support is provided, she says.
“It’s important that adults also have their needs related to deprivation assessed, to make sure appropriate support can be delivered.
“People might need support with transport or to have services delivered closer to where they live. These initiatives can make a real difference to people’s outcomes.”
Kalev is calling for the health system to gather more information from adult patients with leukaemia about their socioeconomic background, lifestyle and other health conditions.
This would allow more research to be conducted into the specific factors that make deprivation a driving force in cancer incidence and death rates.
These factors could potentially include occupational exposure to toxins, smoking, diet, exercise, alcohol use, and co-existing health conditions, such as diabetes or heart, kidney or liver disease.
“There’s an urgent need to elucidate the underlying causes, so patient outcomes can improve across all societal groups,” says Kalev.
The research was funded by Waipapa Taumata Rau, University of Auckland; Bone Marrow Cancer Research Trust and the Norman Family.
Media contact
Rose Davis | Research communications adviser
M: 027 568 2715
E: rose.davis@auckland.ac.nz